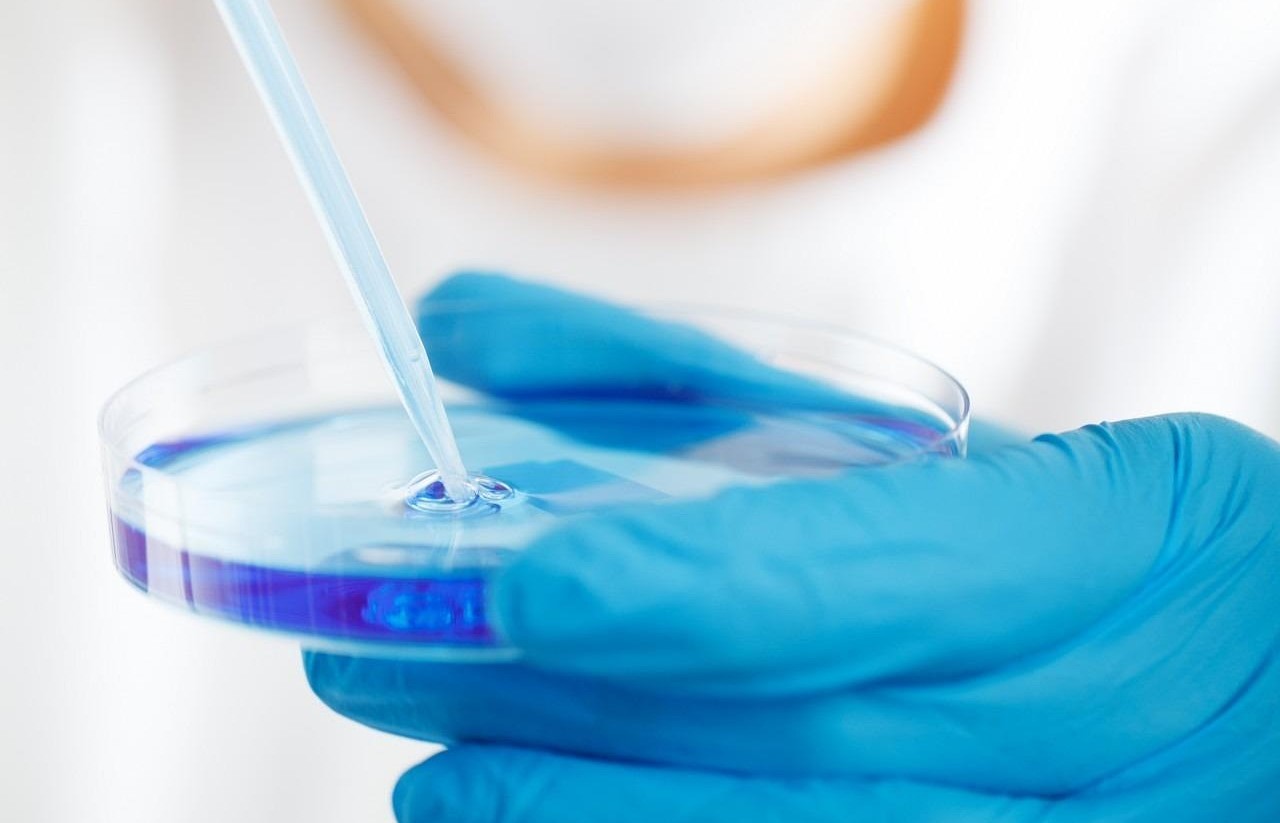

“Todo lo que sucede lleva tal adelanto a nuestra intención que jamás le damos alcance ni experimentamos cómo surgió realmente”, dice R.M. Rilke en el poema Requiem, dedicado a la memoria del poeta Wolf Kalckreuth, quien se suicidó en octubre de 1906, pocos días después de ingresar en el ejército como voluntario. Estas líneas, salvadas las distancias contextuales, bien podrían aplicarse, me parece, a los inciertos caminos que irían a tomar las diversas irrupciones tecnológicas con el devenir histórico.
Por mencionar algunas, ¿cómo imaginar en su momento todas las posibles consecuencias que, para bien o para mal, tendrían a lo largo del tiempo ideas y aplicaciones a partir de la imprenta, el método científico, el automóvil, la televisión, la internet? Solo la mirada retrospectiva, cuanto más amplia mejor, ha permitido ir haciendo ese recuento, ampliando la comprensión, acaso siempre fragmentaria, y el inventario de lecciones aprendidas. ¿Aprendidas?
Aún en la actualidad, con las venturosas capacidades de prospección y procesamiento para la visión más integral potenciadas por las tecnologías de información disruptivas (inteligencia artificial, computación cuántica, realidad virtual y aumentada, etc.), estamos a merced de los derroteros fortuitos, y por ende de los riesgos, ahora incrementados por las complejas condiciones que puedan derivar de esas mismas tecnologías en su conjunto y en el entramado de todo esto con los más diversos ámbitos de la vida.
Algunos piensan que el reto es puramente ético; garantizar que las programaciones, los algoritmos y los usos sean éticamente correctos. Pero, amén de las amplias discusiones sobre lo ético, otros expertos señalan que una de las principales fuentes de riesgo es la capacidad creciente que ya van teniendo algunas de esas tecnologías para generarse cierta autonomía, con capacidad incluso de superar nuestra comprensión.
“Si el volcán va a empezar a hacer erupción, por qué no le tiran una bombeta al cráter para taparlo y listo”, decía en son de broma una apreciada compañera de trabajo. No sé qué tan en broma o en serio, he leído en redes sociales que, ante ese riesgo de funcionamiento autónomo disfuncional de los artilugios inteligentes, bastaría con quitarles el suministro energético que los alimenta. Sin entrar en esa polémica: ¿Y el costo de oportunidad vital?
Si nuestra especie Homo sapiens es tan sabia, ¿por qué nos arriesgamos a inventar tecnologías y aplicaciones tecnológicas que podrían autodestruirnos, como los misiles nucleares, o escapar a nuestro control con implicaciones inciertas, como los algoritmos superinteligentes?, se pregunta, por ejemplo, Yuval Noah Harari en su libro Nexus (2024), sobre una breve historia de las redes de información desde la Edad de Piedra hasta la inteligencia artificial (IA).
Como lo presentara el divulgador científico Eduardo Punset en algunos episodios de su programa Redes, es como si concibiéramos que el curso evolutivo de la vida hizo una apuesta azarosa con el desarrollo del cerebro humano y sus capacidades, a manera de una irrupción “tecnológica” capaz de lo mejor, pero también de lo peor, de la “paz o el espanto”, de la preservación y el exterminio. Parafraseando a Punset, la inteligencia natural en nuestro cerebro vendría a ser “una maravillosa chapuza, un prodigioso apaño de la naturaleza”.
Ya es recurrente, para ilustrar la paradoja de la IA al considerar sus ventajas y desventajas, que se invoque al célebre mito de Prometeo y el fuego sagrado (símbolo del conocimiento), entregado por él a los hombres, a pesar de la prohibición de los dioses; con lo cual desencadenó la ira de Zeus y recibió el castigo de ser encadenado a una roca y torturado por un águila que le devorara las entrañas todos los días, solo para que volviera a crecer durante la noche y repetir así aquel suplicio. Pero, como lo ha verificado la historia, el deseo prometeico nos sigue y seguirá acuciando.
Por esa razón, no han sido pocos las advertencias sobre los posibles riesgos o al menos los que por ahora se puedan vislumbrar en alguna medida, del desarrollo de IA. Eso dio pie, incluso, a un conocido manifiesto, de 2023, en el que un numeroso grupo de expertos pedía una moratoria del desarrollo de la IA; aduciendo que las incertidumbres sobre sus potenciales efectos adversos son, en su criterio, excesivas si no se hace un alto en el camino para reflexionar y regular el uso de esa tecnología.
Al contrario, me parece que ha pasado casi inadvertido sino del todo desatendido, al menos en el país y a nivel de medios de comunicación, la advertencia realizada por otro numeroso grupo de expertos en temas biológicos y afines, en diciembre de 2024, ya no solo para una moratoria, sino para que se detenga cierta investigación sobre la llamada vida espejo (mirror life, en inglés). Esta alude a un tipo de organismos sintéticos basados en un ADN con una estructura especular a la existente a la naturaleza, sobre los cuales no se sabe qué consecuencias pueden tener para el medio ambiente y para la salud si se consigue crearlos y si llegaran a escaparse del control humano.
Según el artículo de la revista Science en cual hacen esa advertencia, “impulsados por la curiosidad y aplicaciones plausibles, algunos investigadores han comenzado a trabajar en la creación de formas de vida compuestas enteramente de moléculas biológicas en imagen especular. Tales organismos espejados constituirían una ruptura radical con la vida conocida, y su creación requiere una cuidadosa consideración.”. Además, el artículo señala que se tiene la oportunidad de prevenir riesgos antes de que se realicen, pues estima que la capacidad de crear vida espejada está, al menos, a una década de distancia y requeriría grandes inversiones y avances técnicos significativos. Sin embargo, me parece que 10 años es como decir “a la vuelta de la esquina”, más tomando en cuenta que uno de los sectores empresariales más interesado es el farmacéutico.
Supe de esa advertencia de la revista Science por casualidad, consultando información del Observatorio de riesgos para las empresas en España, del Institut Cerdà (4ª. Edición 2025). Me sorprendió el llamado del referido grupo de biólogos y afines a una discusión más amplia entre la comunidad investigadora global, responsables de políticas, financiadores de investigación, industria, sociedad civil y el público, para trazar un enfoque apropiado en el camino a seguir. A pesar de mi ignorancia en esa materia, dada la credibilidad que deposito en ese observatorio español, considero relevante que en nuestro país también se estuviera haciendo eco y discutiendo sobre aquel llamado previsor.
Porque si de algo se puede tener seguridad en este mar de incertidumbre, es que el afán prometeico, de negocios y de poder, seguirá adelante con esto a pesar de todas las advertencias sobre riesgos, diríase de alcance suicida algunos, y a pesar de las declaraciones de buena voluntad de gobiernos, empresas y organismos internacionales (como ha sucedido frente a los desafíos del armamentismo nuclear, el cambio climático y la IA, entre otros). ¿Será porque, en parte, dada nuestra tendencia a la cortedad de miras y a la creciente prevalencia de los intereses fragmentarios a nivel de países o corporaciones, cuando no del individualismo e indiferencia actuales, con más razón “todo lo que sucede lleva tal adelanto a nuestra intención que jamás le damos alcance ni experimentamos cómo surgió realmente”, hasta que es demasiado tarde?